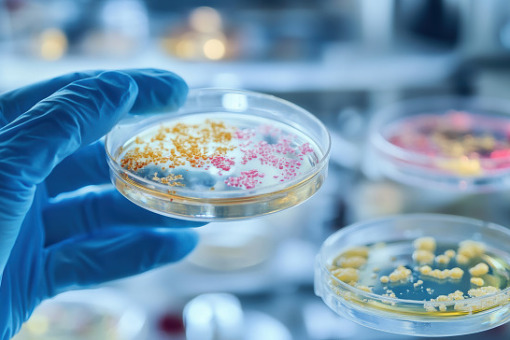

Mikrobiom i dieta zachodnia – poznano mechanizm zwiększający rozwój raka jelita grubego
Dane epidemiologiczne konsekwentnie wskazują, że tzw. dieta zachodnia – bogata w tłuszcze i przetworzone produkty – stanowi istotny czynnik ryzyka rozwoju raka jelita grubego. Mimo silnych dowodów obserwacyjnych, brakowało dotąd precyzyjnego wyjaśnienia mechanizmu przyczynowo-skutkowego na poziomie komórkowym.
Nowe, opublikowane w „Gut” badanie wypełnia tę lukę, identyfikując konkretne szczepy bakterii jelitowych, które w obecności diety wysokotłuszczowej produkują metabolity inicjujące proces nowotworzenia.
Autorzy przeprowadzili wielopoziomową analizę, łącząc dane z modelu świńskiego (genetycznie predysponowanego do raka – APC1311/+), modeli mysich oraz metagenomiki ludzkiej. Punktem wyjścia dla badania była obserwacja, że dieta zachodnia u świń wyraźnie nasilała fenotyp nowotworowy. Zjawisku temu towarzyszył wzrost poziomu kwasu deoksycholowego (DCA) oraz wzmożona proliferacja nabłonka jelitowego. Co istotne klinicznie, podanie cholesteraminy (leku wiążącego kwasy żółciowe) hamowało ten proces, wskazując na kluczową rolę kwasów żółciowych w patogenezie zmian. Aby potwierdzić obserwowaną przyczynowość, naukowcy wykorzystali do badań modele myszy o ściśle zdefiniowanej mikroflorze. Skupiono się na bakteriach posiadających zdolność 7α-dehydroksylacji (7αDH+) – procesu przekształcającego pierwotne kwasy żółciowe w potencjalnie kancerogenne wtórne metabolity.
Wyniki wykazały, że kolonizacja jelit bakteriami aktywnymi w tym zakresie (m.in. Clostridium scindens, Extibacter muris) prowadziła do produkcji DCA i wzrostu liczby guzów.
Ostateczny dowód dostarczył eksperyment porównujący wpływ dzikiego szczepu Faecalicatena contorta z jego zmutowaną wersją, pozbawioną aktywności 7αDH. Myszy skolonizowane mutantem rozwijały znacznie mniej guzów, a w modelach tkankowych imitujących ludzkie jelito (organoidach) odnotowano mniejszą proliferację nabłonka. Analiza metagenomiczna próbek ludzkich potwierdziła te obserwacje: u pacjentów z CRC wykryto częstsze występowanie genów odpowiedzialnych za ten szlak metaboliczny.
Wnioski te dostarczają funkcjonalnego dowodu łączącego dietę z onkogenezą. Otwiera to również drogę do celowanych interwencji – od personalizacji diety, przez stosowanie sekwestrantów kwasów żółciowych, aż po terapie modulujące skład flory jelitowej.











